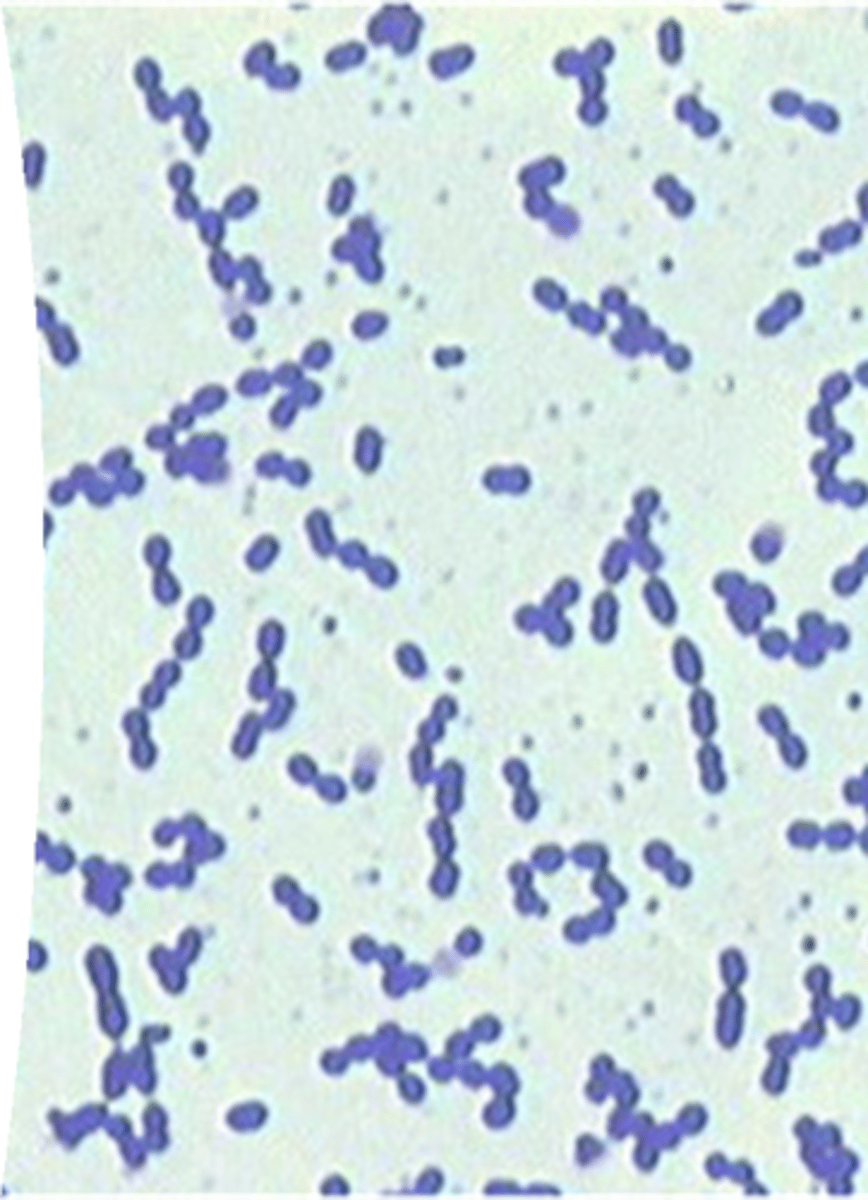

Common Bacterial Disease in Dogs
1/19
There's no tags or description
Looks like no tags are added yet.
Name | Mastery | Learn | Test | Matching | Spaced |
|---|
No study sessions yet.
20 Terms
Leptospira spp. (Leptospirosis)
Gram negative spiral
Affects the renal and hepatic systems
Causes fever, jaundice, vomiting, and kidney/liver failure
Zoonotic

Bordetella bronchiseptica (Kennel Cough)
Gram negative coccibacillus
Affects the respiratory system
Causes dry cough, nasal discharge
Spreads in kennels and shelters

Brucella canis (Brucellosis)
Gram negative coccibacillus intracellular
Affects the reproductive system
Causes infertility, abortions, testicular swelling
Zoonotic

Borrelia burgdorferi (Lyme Disease)
Gram negative spiral
Affects the musculoskeletal and renal systems
Causes lameness, joint pain, and kidney problems
Tick-borne

Ehrlichia canis (Ehrlichiosis)
Gram negative intracellular (white blood cells)
Affects the hematologic system
Causes fever, anaemia, bleeding disorders
Tick-borne

Anaplasma spp. (Anaplasmosis)
Gram negative intracellular (platelets or neutrophils)
Affects the hematologic and musculoskeletal systems
Causes fever, joint pain, low platelets
Tick-borne

Salmonella spp. (Salmonellosis)
Gram negative rods
Affects the gastrointestinal system
Causes vomiting, diarrhoea, and fever
Zoonotic

Campylobacter spp. (Campylobacteriosis)
Gram negative spiral rods
Affects the gastrointestinal system
Causes diarrhoea with mucus or blood
Zoonotic

Clostridium perfringens / difficile
Gram positive rods, spore forming
Affects the gastrointestinal system
Causes diarrhoea, sometimes hemorrhagic
Often stress-related

Pasteurella multocida
Gram positive coccibacillus
Affects the skin and respiratory systems
Causes wound infections and respiratory disease

Staphylococcus aureus
Gram positive cocci in clusters
Causes pyoderma, abscesses, dermatitis, wound infections, otitis externa, post-surgical infections, pneumonia, septicaemia
Affects skin, respiratory, systemic circulation (in severe cases)
Zoonotic
Staphylococcus pseudintermedius
Gram positive cocci clusters
Affects the skin
Causes pyoderma, abscesses, otitis, post-op infections

Streptococcus canis
Gram positive cocci in chains
Affects the skin and systemic circulation
Causes skin infections, pneumonia, and septicemia

Mycoplasma spp.
Pleomorphic
Affects the respiratory and reproductive systems
Causes coughing, infertility, and urinary infections

Corynebacterium spp.
Gram positive club-shaped rods
Affects the skin and urinary systems
Causes skin abscesses and urinary infections

Escherichia coli (E. coli)
Gram negative rods
Affects the urinary, gastrointestinal, and reproductive systems
Causes acute UTIs, diarrhoea, and uterine infections

Enterococcus spp.
Gram positive cocci in pairs or short chains
Causes UTIs, wound infections, otitis externa, endocarditis, peritonitis
Affects urinary, skin, cardiovascular
Zoonotic
Pseudomonas aeruginosa
Gram negative rods
Causes otitis externa, moist dermatitis or hot spots, wound infections, UTIs, maybe pneumonia or septicaemia
Affects skin, urinary, respiratory, sometimes systemic

Klebsiella pneumoniae
Gram negative rods with capsule
Causes UTIs, pneumonia, wound infections, otitis externa, septicaemia
Affects respiratory, urinary, skin, systemic

Proteus mirabilis
Gran negative rods
Causes chronic UTIs (males with stones), struvite crystals, otitis externa, wound infections, occasionally pneumonia or septicaemia
